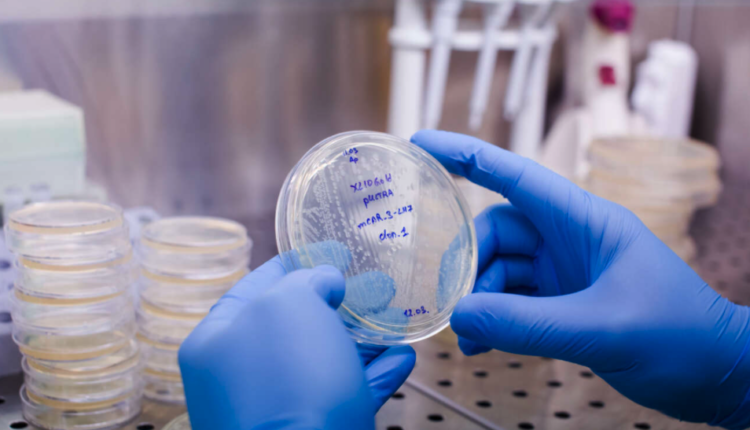

Νίκησαν τον καρκίνο με ανοσοθεραπεία CAR T!
Ασθενείς με χρόνια λεμφοκυτταρική λευχαιμία οι οποίοι υποβλήθηκαν στη συγκεκριμένη μορφή θεραπείας, δεν παρουσίασαν σημάδια υποτροπής της νόσου για περισσότερο από 10 χρόνια! | Γιάννης Δεβετζόγλου
Δύο από τους πρώτους ασθενείς με λευχαιμία στον κόσμο που υποβλήθηκαν στην εξατομικευμένη ανοσοθεραπεία CAR T, παρέμειναν χωρίς καρκίνο για περισσότερα από δέκα χρόνια. Το φάρμακο δημιουργείται από τα ίδια τα κύτταρα του ασθενούς, τα οποία ρυθμίζονται έτσι, ώστε να επιτίθενται και να σκοτώνουν συγκεκριμένους τύπους καρκίνου.
Οπως γράφει ο Guardian, τα αποτελέσματα από τους δύο ασθενείς υποδηλώνουν ότι η αντιμετώπιση της νόσου με CAR T κύτταρα αποτελεί «θεραπεία» και όχι απλώς «αντιμετώπιση», για ορισμένους καρκίνους του αίματος. Ωστόσο, δεν φαίνεται ότι μπορεί να χρησιμοποιηθεί ακόμη για κακοήθειες συμπαγών οργάνων (πνεύμονα, νεφρού, μαστού κ.λπ.).
«Στους συμπαγείς όγκους δεν έχει εξελιχθεί τόσο, διότι τα CAR T κύτταρα που δημιουργούμε, δεν μπορούν να ξεχωρίσουν καλά τα καρκινικά από τα υγιή κύτταρα και ενδέχεται να εξαπολύσουν λάθος επίθεση και να καταστρέψουν ιστούς και όργανα. Δηλαδή να σκοτώσουν αντί να θεραπεύσουν», εξηγεί στο Protagon ο Κωνσταντίνος Συρίγος, καθηγητής Παθολογίας και Ογκολογίας στην Ιατρική Σχολή του ΕΚΠΑ και επισκέπτης καθηγητής Ογκολογίας Θώρακος στο Πανεπιστήμιο του Yale στις ΗΠΑ.
Τέτοιου τύπου θεραπείες γίνονται σε στο Νοσοκομείο Παίδων «Η Αγία Σοφία», τον «Ευαγγελισμό», το «Παπανικολάου» στη Θεσσαλονίκη κ.ά.
Γενετική τροποποίηση Τ-κυττάρων
Στην πραγματικότητα, οι γιατροί λαμβάνουν Τ-κύτταρα του ανοσοποιητικού από τον ασθενή, και με μία διαδικασία γενετικής μηχανικής τα τροποποιούν, ώστε να αναγνωρίζουν και να επιτίθενται στα καρκινικά κύτταρα. Ακολούθως, τα επανεισάγουν με ένεση στον οργανισμό του ατόμου που νοσεί. Ετσι, ο ασθενής έχει την προσωπική του θεραπεία, από τα δικά του κύτταρα.
Τα Τ-κύτταρα είναι ένας τύπος λευκών αιμοσφαιρίων που μπορούν να αναγνωρίσουν και να καταστρέψουν τα ξένα κύτταρα στον οργανισμό, μεταξύ των οποίων και τα καρκινικά. Ωστόσο, επειδή ο καρκίνος έχει πολύ καλές στρατηγικές στην αποφυγή ανίχνευσης του ανοσοποιητικού, τα Τ-κύτταρα συχνά χάνουν το σημάδι τους. Η μέθοδος CAR, τροποποιεί τα Τ-κύτταρα, ώστε να ανιχνεύουν με μεγαλύτερη ακρίβεια τα καρκινικά.
Στις μελέτες που έχουν γίνει μέχρι σήμερα, είχαν μελετηθεί τα CAR T κύτταρα για συγκεκριμένο χρονικό διάστημα. Ωστόσο, η περίπτωση των ασθενών Μπιλ Λούντβιχ και Ντανγκ Ολσον, οι οποίοι έπασχαν από έναν συχνό καρκίνο του αίματος, τη χρόνια λεμφοκυτταρική λευχαιμία (ΧΛΛ), και είχαν υποβληθεί σε θεραπεία με CAR T το 2010, αποτελεί το πιο μακροχρόνιο θεραπευτικό παράδειγμα μέχρι σήμερα.
Το τελευταίο χαρτί ήταν το τυχερό
Οι δύο ασθενείς είχαν δοκιμάσει κι άλλες θεραπείες, χωρίς όμως κανένα αποτέλεσμα. Ετσι, είχαν δηλώσει, ως ύστατη λύση, εθελοντική συμμετοχή σε μία κλινική δοκιμή της πειραματικής, τότε, θεραπείας με CAR T στην Ιατρική Σχολή του Πανεπιστημίου της Πενσυλβάνιας.
Σύμφωνα με όσα υπογραμμίζουν οι ερευνητές στην επιστημονική επιθεώρηση Nature, είναι εντυπωσιακό ότι μετά την πάροδο πάνω από μίας δεκαετίας, ακόμη ανιχνεύονται κύτταρα CAR T στον οργανισμό των ασθενών. «Αυτή η μακρόχρονη ύφεση είναι αξιοσημείωτη και το γεγονός ότι οι ασθενείς ζουν χωρίς καρκίνο τόσα χρόνια, δείχνει τις τρομερές δυνατότητες αυτού του ζωντανού φαρμάκου, που έχει αποτελέσματα στην καταπολέμηση των καρκινικών κυττάρων», δήλωσε ο Τζόζεφ Μέλενχορστ, καθηγητής Παθολογοανατομίας στο Πανεπιστήμιο της Πενσυλβάνιας.
«Είμαστε πλέον σε θέση να συμπεράνουμε ότι τα κύτταρα CAR T μπορούν πραγματικά να θεραπεύσουν τους ασθενείς με λευχαιμία», διαβεβαίωσε ο ερευνητής Καρλ Τζουν.
Η ΧΛΛ είναι η συνηθέστερη μορφή λευχαιμίας στους ενήλικες (περίπου το ένα τέταρτο των νέων περιστατικών). Ενώ η αντιμετώπιση της νόσου με φαρμακευτική αγωγή παρουσιάζει σταδιακά βελτίωση, παραμένει ανίατη με τις συνήθεις θεραπευτικές προσεγγίσεις και τελικά οι ασθενείς αποκτούν αντίσταση στις περισσότερες περιπτώσεις, με συνέπεια πολλοί να πεθαίνουν.
Ο Ολσον είχε διαγνωστεί με ΧΛΛ το 1996 και ο Λούντβιχ το 2000. Και οι δύο δεν ανταποκρίνονταν σε καμία θεραπεία, όμως το 2010, χάρη στην πρωτοποριακή θεραπεία CAR T, εμφάνισαν πλήρη ύφεση, η οποία διήρκεσε για τουλάχιστον δέκα χρόνια (ο Λούντβιχ τελικά πέθανε το 2021 από επιπλοκές της Covid-19).
Η λέξη που δεν λένε οι ογκολόγοι
«Η θεραπεία CAR T έχει υπάρξει εξαιρετικά αποτελεσματική στις συγκεκριμένες λευχαιμίες και λεμφώματα και προσβλέπουμε να συνεχίσουμε τις προσπάθειές μας σε αυτούς τους καρκίνους, ενώ επίσης μελετούμε τα αποτελέσματά της σε συμπαγείς όγκους, μία έρευνα που αναμένεται να εμφανίσει περισσότερη ανάπτυξη τα επόμενα χρόνια», δήλωσε ο καθηγητής Ντέιβιντ Πόρτερ από το Πανεπιστήμιο της Πενσυλβάνιας, ο οποίος συμμετείχε στη μελέτη.
«Οι ογκολόγοι δεν χρησιμοποιούν εύκολα ή συχνά τη λέξη “θεραπεία”. Εγγυώμαι ότι δεν τη χρησιμοποιούμε εύκολα. Οι ασθενείς που θεραπεύσαμε είχαν πολύ προχωρημένο καρκίνο. Η μεγαλύτερη απογοήτευσή μας είναι ότι η θεραπεία δεν δουλεύει σε όλους», πρόσθεσε.
Στο Πανεπιστήμιο της Πενσυλβάνιας έχουν ήδη ξεκινήσει κλινικές δοκιμές CAR T επόμενης γενιάς σε περισσότερους καρκίνους του αίματος, αλλά και σε συμπαγείς όγκους, όπως του μαστού, του προστάτη ή του εγκεφάλου (γλοιοβλάστωμα).
Το 2017 η πειραματική θεραπεία που εφαρμόστηκε στον Ολσον και τον Λούντβιχ, ήταν η πρώτη θεραπεία CAR T που εγκρίθηκε από την Υπηρεσία Τροφίμων και Φαρμάκων (FDA) των ΗΠΑ για παιδιά και ενήλικες με οξεία λεμφοβλαστική λευχαιμία. Το 2018 εγκρίθηκε και για ορισμένα είδη λεμφώματος.
Υψηλό κόστος, μεγάλες δυσκολίες
Αρκετές χιλιάδες ασθενείς έχουν ήδη κάνει χρήση αυτών των θεραπειών, οι οποίες όμως έχουν υψηλό κόστος, ενώ ενέχουν κινδύνους και είναι τεχνικά δύσκολες, γι’ αυτό παραμένουν η τελευταία λύση, και χορηγούνται όταν όλες οι άλλες θεραπείες έχουν αποτύχει.
Επιπλέον, όπως υπογραμμίζει το Nature, τα CAR T δεν πετυχαίνουν ύφεση διαρκείας σε όλους τους ασθενείς, καθώς υπάρχουν αρκετοί που υποτροπιάζουν. Δεν είναι, ακόμη, σαφές πότε αυτό συμβαίνει και γιατί τα CAR T φαίνονται πιο αποτελεσματικά στην οξεία λευχαιμία από ό,τι στη χρόνια.
Επίσης, δεν είναι ξεκάθαρο αν η θεραπεία σκοτώνει όλα τα καρκινικά κύτταρα στο αρχικό στάδιο ή αν τα Τ-κύτταρα συνεχίζουν να καταστρέφουν και πολύ αργότερα τα όποια καρκινικά κύτταρα, πριν αυτά φθάσουν σε ανιχνεύσιμα επίπεδα.
Ακόμη, η θεραπεία CAR T έχει προκαλέσει σοβαρές παρενέργειες σε μερικούς ασθενείς, όπως υψηλό πυρετό, επικίνδυνα χαμηλή πίεση ή και σε κάποιες περιπτώσεις θάνατο.
Ενδείξεις της θεραπείας
Χιλιάδες ασθενείς σε όλο τον κόσμο υποβάλλονται σήμερα σε θεραπείες με CAR T, καθώς είναι εγκεκριμένη σε Ευρώπη και ΗΠΑ για ορισμένες μορφές αιματολογικών κακοηθειών. Σε αυτές συμπεριλαμβάνονται:
- Η οξεία λεμφοβλαστική λευχαιμία Β-κυττάρων
- Το διάχυτο λέμφωμα από μεγάλα Β-κύτταρα
- Το πρωτοπαθές λέμφωμα μεσοθωρακίου από Β-κύτταρα
- Το πολλαπλούν μυέλωμα
- Το λέμφωμα μανδύα